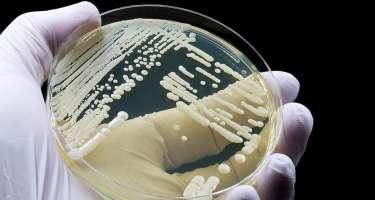

Gənclər arasında sürətlə yayılan xəstəlik - Səbəbi nədir?

Gənc yaşda Parkinson xəstəliyinə tutulma halları artmağa başlayıb.
Nevroloq, Dr. Gülten Özdemir yaşlılıqda daha çox rast gəlinən Parkinsonun artıq gəncləri hədəf almasının səbəblərindən danışıb.
"Bəzi tədqiqatlar göstərir ki, quyu suyu, insektisidlər, qurğuşun və civə kimi ekoloji toksiklərə məruz qalmaq bu halların artmasında rol oynaya bilər", - deyə həkim bildirib.
Nevroloqun sözlərinə görə, beyin hüceyrələrinə təsir edən Parkinson xəstəliyi adətən 60 yaşdan yuxarı insanlarda müşahidə edilirdi, lakin son illərdə xəstəliyə 40 yaşın altındakı insanlarda da rast gəlinir.
"Parkinson Alzheimerdən sonra ikinci ən çox görülən nevroloji xəstəlikdir. Son illərdə hətta 20-30 yaşlarında olan insanlar da Parkinsonla üzləşə bilir", - deyə G.Özdemir qeyd edib.
Nevroloq Parkinson xəstəliyinin əlamətləri haqqında məlumat verib:
"Beynin müəyyən anatomik bölgələrində dopamin ifraz edən hüceyrələrin degenerasiyası və itkisi nəticəsində Parkinson xəstəliyinin simptomları baş verir. Degenerasiyanın dəqiq səbəbi məlum deyil. Alimlər ispan qripindən sonrakı illərdə Parkinson xəstəliyinə yoluxma hallarının artıb-artmadığını və eyni artımın koronavirusdan sonra müşahidə olunub-olunmadığını araşdırırlar".
Həkimin sözlərinə görə, xəstələrin 25 faizində titrəmə olmur.
"Hər titrəmə Parkinson xəstəliyi ilə əlaqəli deyil. Ancaq Parkinson xəstəliyinə diaqnoz qoyarkən xəstənin hərəkətlərinin yavaşlamasını nəzərə almaq vacibdir. Parkinson xəstələrinin gündəlik həyatlarını aktiv şəkildə davam etdirə bilmələri üçün velosiped, yoqa, üzgüçülük, pilates, gəzinti kimi fərdi fizioterapiya proqramları və məşqlər çox əhəmiyyətlidir. Xəstəliyin müalicəsinin məqsədi simptomları azaltmaq və xəstələrin həyat keyfiyyətini yaxşılaşdırmaqdır.
Xəstənin yaşı, xəstəliyin mərhələsi, istifadə olunan dərmanların əks təsirləri müalicə prinsipini müəyyən edən amillərdir. Əsas müalicə azalmış dopamin səviyyəsini artırmaqdır. Xüsusilə dərmana ilkin mərhələdə, yəni dopamin anbarları tükənməzdən əvvəl başlamaq vacibdir".
Nevroloq vurğulayıb ki, xəstəliyin gedişində depressiya və demans kimi əlamətlər də yarana bilər.
"Xəstələr yaxından izlənilməli və şikayətləri olduqda müvafiq müalicə təyin edilməlidir. Əgər Parkinson diaqnozu qoyulan xəstə dərman müalicəsinə adekvat reaksiya vermirsə və dərmanla əlaqəli əks təsirlər yaşayırsa, o zaman Dərin Beyin Stimulyasiyası tətbiq olunur".//Medicina.az
Oxşar xəbərlər

Xəstəlik vərəqini kimlərin ala biləcəyi açıqlandı
Bugun.az
Avropada bu xəstəlik sürətlə yayılır
Bugun.az

Azərbaycanda yayılan virus nədir?
Tibbi məlumatlar

Ceyhun Hüseynov RGUDMŞ İdarə heyətinin üzvü seçili...
Son Xeberler

ÜST-dən qorxudan AÇIQLAMA:
Son Xeberler

Lənkəranda baş verən kütləvi davada
melumat.tv